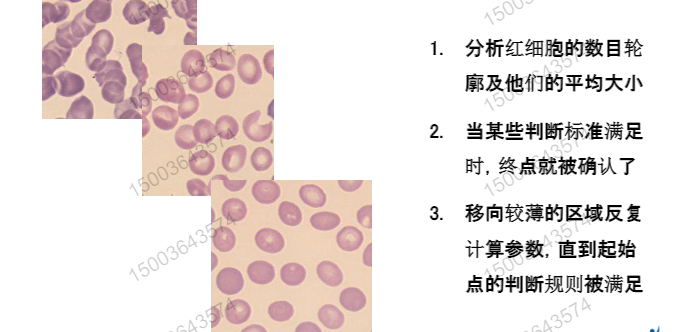
在这里插入图片描述

一 M2M连接
安装调试:
M2M的组成部分:IPU电脑\laboman电脑+M2M(路由器)+SNCS服务器+IPU多仪器的多电脑+(HUB交换机+IPU电脑+laboman电脑)
注意:一个M2M路由器只能最多安装3个IPU电脑,如果连接多个电脑我们则需要安装多个M2M,一个IPU电脑可以连接多个仪器
M2M接口必须且只能在LAN端口上,别的接口没有作用
二 M2M的安装步骤
基础配置:1 插卡上电(这里的卡指的是SIM电话卡,初次使用需要激活(1-30分钟))
2 安装天线,一长一短,一粗一细
3 观察LED灯指示状态
4 如果使用无线网连接M2M则是自动获取地址端口,则使用有线需要设置网络模式和端口IP地址的匹配
指导:如何设置有线连接端口设置网络
控制面板-网络ID和Internet-网络连接-属性-网络设置
注意:如果M2M网络无法获取地址,则需要重置M2M,重置之后则需要在浏览器中访问M2M网关,输入IP网址,192.168.8.1访问管理页面
附加网络配置:登入网址——更多设置——修改IP
如果是双网关的情况下:需要配置路由
网络设置指导:
1 如何取消自动获取,设置手动获取配置IPU或laboman主机网卡IP地址
控制面板——网络和Internet——网络连接——本地连接(属性)——Internet协议版本4(TCP\IPU4)——属性——(填入IP地址,子网掩码,首选服务项)

网络配置——绑定MAC地址与固定IP(固定物理地址)——数据准确性
指导:查看labomna或IPU主机的MAC地址与IP地址并记录
控制面板——网络和Internet——网络连接——状态——详细信息——固定物理地址IPU4地址
绑定MAC-物理地址
指导:电脑WiFi连接M2M网络地址并在浏览器输入192.168.8.1
在更多设置——IP——静态IP地址绑定——MAC
系统配置:host脚本
指导:1 管理员host脚本运行
2 检查hosts脚本是否运行成功
C盘—system-drivers-etc-打开
Teamviewer配置及使用
1 直接打开
2 点击高级配置设置高级密码
指导:其他-选项-高级-显示高级选项-高级-导入-tv-setting-打开
3 高级密码输入成功(其他)-选项-输入密码-导入成功
最后可以在laboman中设置工具加入路径添加
---医院设备仪器组成部分---
仪器+laboman+IPU电脑+医院LIS系统(医院信息报告系统)
交互流程
单向:仪器发送结果——laboman/lis
双向:lis/laboman发送指令到host指令信息包括病人信息项目指令信息Host发送结果到Laboman/lis
样本完整的双向流程
1 上机前,lis系统把病人信息发送到指定文件夹,laboman读取病人信息记录数据库
2 lis将指令发送到laboman根目录下laboman解析文件
3 标本上机开始检测(仪器)--询问--laboman检测指令--laboman通讯程序回复检测指令
4 检测结束,仪器将指令上的检测结果发送给--laboman--laboman通讯程序结果接受后解析程序结果--发送给数据库和指定文件到lis
CT-90和laboman的交互交流
标本上机轨道询问指令————轨道分配标本到仪器————仪器扫码向laboman指令,laboman回复————仪器接受指令并作出相对应的项目————等待时间是否做出复检(若有复检指令则执行并给出结果)————标本架出仪器后,轨道扫指并向labaman询问各标本指令(如有推片,CRP,糖化指令————若有标本在仪器中有指令并没有给出结果,则此阶段给出指令让轨道继续做出分配——正常情况下如果轨道询问没有指令后归档)
lis交互子程序:
CDF-LIS:读取LIS传入的检验指令RET文件,将检验指令保存到相对于的文件夹中
CDF-IN:读取LIS传入的病人信息,存入数据库
CDF-OUT:将检验结果图像,报警信息,推片状态,样本位置等各个信息保存成CDF文件传给LIS
laboman日志介绍
一,日志打包工具
点击工具-打包日志
选择打包天数和需要查看的仪器日志信息
确认无误点打包
打包成功后会有提示窗口,点击确定
在laboman路径下找到相对应 的打包日期压缩包的文件
打包日志:laboman软件内部日志,各个仪器的日志(laboman与仪器交互的数据和解码日志)
案例分析
一.laboman不能显示病人信息
病人信息来源:LIS
1.确认LIS是否发送了病人信息(病人信息备份)
2.检查病人信息格式
举例:2021-05-09 12:45:00,XN,1…外科,1504,李四,4221,张三,女,门诊,,56岁,,,,开放性骨折,,YPJ,,,MZ00123
二.推片机不能打印LIS短号
LIS短号来源:LIS–laboman–仪器
1.检查laboman是否接收了LIS短号(laboman界面是否显示)
2.检查推片机是否向laboman询问指令(日志)
3.检查仪器设置(推片机打印内容设置)
三.XN流水线推片不执行推片指令
两种情况:标本到了推片机未推片,标本未到推片机直接从轨道回去
1.确认存在推片指令来源
2.查看CT90 progress 3. 检查轨道及推片机状态设置
四.质控无法自动传输到laboman
1.查看日志 2.检查仪器自动审核,自动输出设置
五.XN全部标本执行默认指令
1.查看日志,是否有指令询问记录
2.检查是否有LIS指令
3.检查laboman默认指令设置
六.TS10标本不归档
1.查询日志,确认日志归档指令来源
2.确定labomanTS10区域设置
3.确定仪器状态
七.标本不自动DI阅片
1.检查是否触发阅片指令规则
2.检查SP10通讯设置
3.检查仪器状态
-----安全基础------
一.操作系统安全
安装下载laboman时,建议官网下载,并且必须关闭防火墙
二.网络安全
合理设置网络地址,避免地址冲突或网络不可达
注意:流水线网络与医院内网不可直接互联
常用指令:1.ping 2.trscart(检查网络跟踪点)3.telnet(检查网络端口)
laboman:
1服务器配置
控制面板-系统安全-管理工具-ODBC(32位)-login
2客户端(laboman工作站)配置

3返回ODBC标签页,测试数据库连接正常,则正确
4启动laboman软件
laboman新功能介绍
*laboman问题自排查工具
自排查工具可以自动分析laboman中的日志,排查问题标号就能分析标本上机流程与判断标本存在问题
流水线功能:
多线推片共享LIS短号(如果要共享两台或多台,需要在共享文件的路径下添加路径,如:192.168.0.111laboman;192.168.0.112laboman)
指令共享功能
TS区域设置
输出TAT时间
多线程共享LIS短号
1.需要两台laboman电脑网络互通2.将需要显示的推片lis短号的laboman文件夹共享
例如:若有一台XN2000和一台XN9000流水线推片是没有短号的,因为XN2000 的标本上没有XN9000的触发规则(一 一配对)
如果要实现两台laboman电脑网络互通,则需要显示推片lis短号的laboman文件共享laboman可以共享两台或多台,只要是添加路径
****TS区域设置*****
1.仪器设置注意事项
仪器划分的区域号对应的是laboman,TS界面上对应的区域号仪器上的区域可以使用在多个架位划分
2.laboman开启TS区域设置
打开CT90通讯程序——CT90——连接TS-10——勾选
3TS区域判断原则简介
设置TS10项目优先级,项目优先级在通过排布计算,按顺序排序
TS (筛选功能)
区域优先级是laboman判断标本区域的顺序,标本会按区域顺序往下判断,直到对应中判断项目
1,LIS遗留项目,用于区分由lis发送过来的包含非血常规项目指令的标本,可以选择是否完成血常规项目检测
CRP和血常规一起处理
2,超出危急值,当标本的检验结果超出labomand 的检验项中的危急值符合条件
3,结果未做出,区分laboman中的结果不存在的标本
4,XN误码:没有收到标本结果,laboman在TS归档时都没有收到XN结果
5,默认区域:不符合上述任何已选条件的标本存放
输出TAT时间
指导:设置--系统设定勾选--接受TAT数据--cdf-out设置
新模式支持
DPS取图功能,输出UC异常标志,SPG8传输机身号,镜检审核功能
DPS取图功能
仪器设定
1.IPU工程师模式,选择serving setting 选择host右侧选中如图,选项将volue设为1
SP.G8传递机身号
SAA项目仪器
1.PA系列仪器支持
PA800和PA990pro支持同时做CRP和SAA项目而PA900和PA990只能每台仪器单独做CRP和SAA
注意:PA系列的仪器都叫做全自动特定蛋白分析仪
凝血流水线支持
凝血流水线与laboman工作流程
1.标本上机扫码后向laboman询问指令
2.标本分配仪器后仪器扫码向laboman询问指令
3.检测完成,若有复检模块则返回复检模块
4.复检模块扫码询问指令,轨道分配
5.仪器询问指令完成检测
6.返回初始区域
注意:凝血仪普遍是CA系列和CS系列,主要是CS-5100,全自动凝血仪
镜检审核功能
功能:主要的目的是对于老师手工镜检的阳性样本在laboman中填入镜检项目数据通过设置的镜检审核规则判断通过审核后在镜检审核栏显示不通过的拦截,并将信息发送给lis
相当于是智能审核
CT90设置
仪器项目选择,点击measurement item setting勾选流水线中CS-5100可支持的项目,如若主机发送没有勾选的项目,CT-90会出现通讯错误的情况
复检规则功能:
1,规则名称-用于将设置的规则命名
2,项目规则-设置触发规则的项目范围如:
3,稀释新设置-触发规则后给仪器发送复检的稀释倍数
4,........
laboman–TS 10基础
1.TS-10简介:试管分选处理系统(前处理)
!提高血液检测流水线处理能力的大容量试管管理系统
!可根据指令自动挑选和分类试管
!可灵活定义试管分类区域
!通过自动化管理试管,提高检验工作效率
TS-10筛选系统(利用抓手在设置区域规则laboman)
把所有的标本进行筛选,按指令分选
TS-10 的工作原理
#如果标本不满足设置的各个区域TS-10该如何处理
laboman--->TS 10--->不会归档,直接被TS-10搞会回收区
#如果每个标本都归档,该如何处理?
laboman TS区域设置默认区域,如果不满足条件,则全部最后返回到默认区
二,TS-10划分区域三个阶段
与医院沟通各个区域设置标本的标本类型————>TS划分区域————>laboman优先级,符合各个区域的划分
三,TS区域划分
1.划分--8个托盘(按需求划分,一般是两个托盘划分一个区域)
2.对于关系
laboman设置
1,初始设置
laboman CT90设置——>连接TS-10——>TS10菜单
2,项目优先级设置
4,判断原则
按照区域优先级判断筛选,满足条件就会被拦截
5,优先级设置原则
项目优先级决定区域优先级大小
案例:TS设置案例
医院有大量标本,TS-10上面一共有八个托盘,这里的区域划分刚好是8个,那么我们把TS-10的八个托盘各划分一个区域会怎么样
*正常区域划分过少,医院老师需要频繁更换区域托盘
XE-2100(全自动血细胞分析仪)

WBC Diff检测原理
1,吸血--从SRV中吸取血样和试剂
2,溶血--STROMATOLYSER -4DL溶血素溶解RBC-WBC细胞膜被轻度破坏
3,染色(DNA和RNA)--STROMATOYSER-4dS试剂染色
4,分析--通过侧向散射光(内部结构)和荧光信号(DNA,RNA)分析散点图
RET检测原理(网织红细胞)
1,吸血 2,染色 3分析
IMI 分析过程
1,吸血 2,溶血 3,分析
鞘流系统的优点:
^保证血样从微孔的正中通过
^消除重合通过的产生的异常波形
^保证结果(RBC_HCT,PLT )的准确性重复性
^免除日常保养
鞘流原理

方法:流式细胞加半导体激光
流式细胞仪原理

XE-2100单机配置
XE-2100特点
流式细胞(半导体激光技术),网络服务能力
每小时150个处理样本能力,7个独立通道,精确可靠的结果
NRBC 有核红细胞的计数,实时随时检测的模式
网织红细胞检测的临床意义


UF-1000i(全自动尿有形成分分析仪)
检测原理:红色半导体激光,DNA和RNA的染色技术,流式细胞计数
特点:光源系统:红色半导体激光
1.激光强度不容易减弱
2.故障率低 3.成本低
二.DNA /RNA 的染色技术
特异性的核酸荧光染料染色技术,对细胞膜,细胞核,细胞质进行特异性的核酸荧光染色
半导体激光流式细胞/核酸荧光染色技术
检测通道
双通道,沉渣通道,细菌通道
1.沉渣通道(各有形成份):沉渣染液,沉渣稀释液,混匀测定
2.细菌通道(仅细菌):细菌染液,细菌稀释液,混匀测定
UTIC(尿路感染症)
判断标准:wbc,BACT
质控:原厂配套的具有溯源性的两个波度水平的校准品和配套的质控品
检测流程:
1,非离心尿,原始上机 2,定量 3,稀释染色 4,FCM测量 5,数据分析
6,显示结果 7,结果报告
可采用手工和自动两种进样方式任选

定期维修保养指导书



UF-1000i电动马达故障————PCB NO1274损坏
PCB烧坏原因:进样器马达短路或者卡死造成的PCB NO1274烧坏,处理故障时,优先检查选择器的3个马达,配查电压电阻的值是不是正确的,排除马达故障后在进行PCB NO1274的更换
UF-1000i电压调整
故障表现:当开机或仪器休眠后启动机器,压缩启动滞后或者是启动不了
感觉为压缩机电压输入低,测量后,压缩机输入电压为83.2V,故而调整启动电压
UF-100i和AX-4030共同组成尿流水线
尿流水线

AX-4030
AX-4030(全自动尿液分析仪)
仪器规格:AX-4030的项目测定,GU,Pro,uro等
试制测定:色调,浓度,比重
尿液分析基础
尿液来源:泌尿系统(肾脏,输尿管,膀胱等)是人体机制排泄的代谢的终产物 ,是保持和控制人体液各种成分浓度的平衡
肾脏的三大生理功能
1.排泄机体代谢废物,维持机体内环境
2.调节水,电解质,酸碱度
3.内分析功能
各种原因引起的肾损害
1,蛋白质滤出,导致低蛋白的血症,引起水纳潴留,蛋白质在肾小管中形成管型
2,血细胞的滤出:肾性血尿
3,代谢产物的潴留,BUN,Gr,代谢酸性
尿理的病理情况:颜色,PH,比重,浓缩稀释功能
现代尿常规分析
1,物理检测 2,化学成分 3,成形成分的检测 4,镜检确认
尿红细胞质与量的,形态和计数
尿液分析系统
AX-4030+UF-1000i+镜检
AX-4030(试纸检测法)
不易受脏物的影响,不易受白浊局的影响
常规尿液分析:理学,化学,有形成分
UF系列的FCM法:尿液细菌检测和计数的有效方法
DI-60/CF-60
DI-60(全自动细胞形态分析仪--阅片机)
CF-60是SP-10和DI- 60之间传输的系统
配置:XN-9000
XN-3000,落地式,带台车,SP-10,推片机
XN-9000--通过CV-70能够扩充到5个模块
CF-60技术参数
处理速度--大于等于30张每小时
确认可使用的玻片,弹夹玻片盒,5个空的弹夹玻片盒,片盒存储,预估循环计数,可以连接状态的指示灯
DI-60的技术参数
操作流程
1.CF-60 从玻片盒取出拨片
2.CF-60 向DI-60传递/从DI-60接收拨片
3,CF-60 放回拨片到弹夹玻片盒
SNCS
经由IPU连接到SNCS(同SP-10)
DI-60信息发送,日志,备份,循环计数
DI-60的目镜和物镜
10X物镜(寻找单层细胞,单层细胞定位)
100X物镜(寻找RBC形态的单层细胞,RBC形态特征描述)
工作流程:拨片在通过SP-10(推片机)到CF-60的连接到DI-60仪器的传送
1.读取玻片上的条码,向lis寻求指令
2.lis传送指令
3.10X物镜寻找单层细胞定位
4.盖油,50X物镜寻找RBC的单层细胞并捕获细胞图像
5.RBC 特征的预定性,100X物镜聚焦并捕获WBC图像
6.WBC的预分类,寻找单层细胞并先定位
7.保存坐标
特征提取:基于6组主要特征
形状,颜色,质地,检波,函数概率,技术


寻找WBC单层细胞

DI-数据库介绍
分析处理数据库,数据导出数据库,涂片扫描数据库,能力测试数据库
XN -2000的安装
XN的组成部分SA-20,UC-17和头,有染液,试剂,稀释液
XN
检测原理,RET通道---网织红细胞计数
RET简介:网织红细胞
1.未完全成熟的红细胞
2.染色后成点状或网状结构为RNA
3.数量的增减直接反映骨髓的生成能力
XN通道核酸荧光染色(染液,稀释液)
RET是RBC红细胞的幼稚细胞阶段,因此贫血的早期,首先是RET发生变化,然后才是常规红细胞参数发生变化,因此RET参数可以作为贫血早期的判断指标
RET(网织红细胞)发生变化导致RBC红细胞发生变化
PLT-O:光学法
核酸荧光染色流式细胞术
检测通道:网织红细胞RET通道
PLT-I:液流聚焦电阻抗技术
利用液体层使细胞排成单例通过的检测孔
WDF通道--白细胞分类通道(WDF通道对白细胞进行分类)
WDF通道的要点:
1.WDF散点图基本上和XE系列的DIFF通道无区别
2.试剂得以改良(溶血剂的作用较XE系列的稳定)
3.淋巴细胞和MoMo(单核细胞)得以更加明确的划分
!XE仪器难溶红细胞干扰案例
推片镜检,WBC镜下计数和DIFF通道WBC总数较为接近,最后以DIFF通道WBC结果报告
!红细胞溶血不良——XN主屏
WNR通道要点
1.由于在CBC模式下该通道用于WBC测定,因此可以在全体样本中测得NRBC计数,以及由NRBC数修正过的WBC数据
2.由于采用荧光染色进行检测,红细胞没有被染色,所以不存在细胞溶血不良造成的影响
3.试剂开发中调试的过程中,XE的溶血剂中只有阳离子界面的活性剂,而WNR的溶血剂中还增加了阳离子的界面活性剂,区分NRBC与WBC解决脂肪问题
WPC通道的主要作用:白血病的初步筛选,降低复检率,HPC的定量检测用于造血干细胞特指干细胞采集时间的判断
血液学基础
血液分为血细胞和血浆
血细胞的组成由红细胞,白细胞,血小板,PLT
血浆的组成成分 是水分,固体水分
血液的标本采集方法--(皮肤采血法(手指,耳垂,足跟,拇指),静脉采血法(肘部静脉,颈部静脉))
应用范围:血常规,全自动血液分析检查,全血葡萄糖,临床生化检验,临床免疫检验
红细胞的检查
1.红细胞计数及血红蛋白测定
2.红细胞形态检查
3.红细胞比容测定
4.红细胞平均指数计算
5.网织红细胞的计数

血红蛋白的结构:
血红素和珠蛋白
临床意义:红细胞和血红蛋白减少(贫血)
生理性:
1.妊娠中后期的孕妇 2.6个月到2岁的婴幼儿 3.老年人(造血功能减退)
病理性:1.生成减少 2.破坏过多 3.失血
1,相对性 的RBC 增多:连续呕吐,反复腹泻,大面积烧伤
2,绝对性RBC增多:继发性(生理因素:新生儿RBC相对较多,精神因素:运动员等高山居民) 原发性(真性RBC增多症)
红细胞异常
1,红细胞大小改变:缺铁性贫血,遗传性球形红细胞增多症
2,大红细胞:溶血性贫血及幼稚细胞性贫血
3,巨红细胞和超巨红细胞,巨幼细胞贫血
4,细胞大小不均,严重的增生性贫血
HCT的临床意义
1,红细胞比积增多:真红,血液浓缩
2,红细胞比积下降:各种贫血
3,临床上常以红细胞数,HB量来计算几种红细胞的平均值,有助于贫血和鉴别诊断
HISCL仪器的介绍
HISCL-5000(全自动化学发光免疫分析仪)
检测原理:高敏化学发光酶免疫测定法
提高实验室的质量和效率(微样本用量,高灵敏度,快速检测(任意项目只需要17分钟,200测试/小时),极速用户体验)
HISCL-5000的基本构成模块

HISCL-5000试剂/耗材/清洗液
耗材:一次性加样头,反应杯,过滤薄膜,垃圾袋
试剂:R1-R3,R2(磁性微粒),样本稀释液
清洗液:反应清洗液,管路清洗液,分注针清洗液
HISCL-5000反应杯/一次性加样枪头
分别有不同颜色的舱口,反应杯包装袋(绿色),TIP包装袋(粉色),一次性TIP和反 应杯有自动整理和供应系统,可直接从包装袋投入到供应单元

样本架的种类

HISCL-5000的工作流程
专用反应杯--专业一次性吸样头--吸样监控系统--过滤薄膜


HISCL-5000的日常维护保养
1.执行标本前,检查所有的消耗品是否充足
按压蓝色按钮,唤醒机器,使机器处于就绪状态,添加反应杯和一次性加样枪头(tip头),切记不要超过红线的位置
2.补充探针清洗液,补充probe washing solution及清洗容器瓶
3.补充R4R5试剂
4.倒空废弃物,清理废弃物箱内的cuvettte和TIP,准备当天所需要测试项目的试剂
^准备当日所需的项目的试剂所对应的测试的试剂(R1R2R3)(R2带磁性颗粒)
^注:新开封的R1R2R3试剂瓶必须按压到底,确保试剂瓶底部无缝隙
^R2试剂需将磁性颗粒摇匀
长时间关机:长时间未使用的仪器,等待仪器进入到就绪的状态,执行以下的程序
主界面———维护——-执行维护———自动清洗prode和line
主界面———维护——-执行维护———搅拌试剂
关机前的准备工作,更换过滤薄膜(需要时)

*用干浸水湿布擦拭仪器表面并用干布擦干
*清空废液罐内的废液
若直接连接下水道侧检查排水是否顺畅,更换过滤器(每100个测试)执行清洁样本吸嘴
清洗样本针
*使用附件箱内的清洁海绵,需要导入无水酒精至瓶内,将样本针插入海绵正中圆孔内上下移动数次进行针头清洁

倒空防逆流瓶
*检查防逆流瓶内是否有液体,如果内部有液体,顺时针旋转取下瓶内液体,并将防溢流瓶安装回归原位置
压力调整
1,如果需要时,对仪器进行压力调整
2,点击维护——执行维护——压力调整——开始

HISCL-5000维修程序
1,通向服务维护
传感器电磁阀,样本条码测试,位置调整
HISCL-5000部件介绍
1,试剂制冷单元及连续加载单元











HISCL-5000的日常保养维修
1,一次性加样头(TIP)堵塞




2反应杯堵塞












HISCL-5000的操作
1,开机前的检查:
垃圾箱检查,废液桶检查,2处逆流瓶检查,关机状态下进行仪器的表面清洁

2,开机
打开IPU和仪器电源,选择用户登录,仪器进入初始化的状态,达到目标温度仪器初始化结束

3,更换试剂,扫码上机


4,补充消耗品
反应杯(绿色),TIP头(粉色)
5,检查过滤薄膜(10000次)
6,更换清洗液

XN-2000安装






















CS-5100(全自动凝血仪)


样本针:A、样本针A具有穿刺功能和吸引正常模式的样本
B、样本针B吸引2次分配样本或微量模式的样本
多波长的检测部










血液学项目的检测
世界人口死亡原因分析:
血栓性疾病,感染,癌症,意外事故,肺部基本,艾滋病
我国的心血管病,血栓性病要面对血液科,心内科,神经内科,传染科
凝血常规筛查七项:PT,APTT,Fby,TT,AT,Fbp,D-Dimer
涵盖血液的凝血系统,抗凝血系统和纤溶系统
为临床提供患者血栓与止血功能的基础信息,能实现自动化快速检测,成本低,便于普及
血凝学项目介绍:常规七项(主要包括前四项)
PT结果的报告方式
秒数,百分比活性,PT比值(PTR),病人值/正常参考值
PT检测的差异性
试剂来源不同,组织凝血酶的类型
国际敏感度指数-ISI
为使不同敏感性的组织凝血酶在检测中能得到同样结果的所制定的共同敏感性指标
规定试剂生产厂商的产品必须有ISI
ISI指数接近1.0,试剂敏感的越高
PT(凝血酶原时间)配套试剂
单试剂:Thrombochech PT
兔脑粉来源
冻干品,复溶液为蒸馏水
开瓶有效期:2-8摄氏度保存7天
APTT(活化部分凝血酶原时间)配套试剂
激活剂:鞣花酸
液体试剂
开瓶有效期:2-8保存一个月
双试剂:TC缓冲液
冻干品,复溶液为蒸馏水
TC缓冲液的作用:稀释样本
如何设置dFBG ?
准备定标液(含FBG的赋值)一支,将其做PT测定,在结果图形中记录DH值,在PT标准曲线设置DFBG参数中将DH值与定标液FBG浓度输入
使用限制:只有当PT结果是正常时,dFBG 和FBG相关性良好
TT试剂
目前使用Dade-Berhring试剂
Buffer solution 是fest tromb.....d 的复溶液
生物安全
一般是指现代生物技术开发和应用对生态环境和人体健康造成的潜在威胁下及时其所采用的一系列有效预防和控制措施
凝血-5100 的概要
全自动凝血仪:CA-100----------CA系列到CS系列
cs-5100的设计理念-提供优越性能,满足高端客户的需求,综合能力最快
凝血5项/6项/7项的检测速度均为200Test/小时左右,相比CA-700提高30-50%
成本控制
试剂仓,多波长检测技术,减少重测,节省试剂
质量保证
产品特征:最快检测速度400测试/小时
4种检测方法学:凝固法,免疫散射比浊法,发色底物法,聚集法
穿刺/开盖和微量样本随机进样
CS-5100常规试剂及消耗品
凝血酶原时间(PT)
临床意义:手术前筛查,先天性外源性凝血因子缺乏获得性因子,维生素K肝脏疾病,口服抗凝剂治疗监测
PT试剂操作
将试剂从冰箱中取出并平衡到室温
按试剂瓶标注的量加入纯水
将橡胶塞盖上并静置5分钟使周围粉末溶解在轻柔翻起瓶子
在30分钟37度水浴卵育后上下混匀瓶子
在室温下静置10分钟之后在混匀瓶子
活化部分凝血酶原时间(APTT)
APTT的临床意义:
检测内源性凝血系统的活性
肝素治疗的检测
狼疮样抗凝物的测定
VEII,IX,XI,XII因子的检测
APTT的试剂操作
从冰箱取出试剂轻度上下混匀
纤维蛋白(FBG)
临床意义:纤维蛋白原含量异常,DIC的诊断及监测
监测纤维蛋白原溶解治疗
Fbg试剂操作
将试剂从冰箱中取出并平衡到室温,轻柔按瓶身标识的量加入纯水
将胶塞盖下并放置于室温内5分钟以允许周围粉末溶解然后混匀
CS-5100
流水线:流水线的架子不能与CS-5100单机架子混用
单机检测:流水线的架子不能与单机架子混用
急诊样本分析主要以手动分析
急诊样本不能使用有盖样品管
CS-5100的检测原理:
1凝固法:血液凝固的过程(在纤维蛋白原转变为纤维蛋白时浑浊发生变化)
2发色底物法:合成显色底物显色的过程
3免疫比浊法:抗原抗体的特异性反应过程
4血小板聚积:利用磁珠搅拌判断器凝固时间(凝固程度)
物理方法:HIL(标本通过不同波长吸光测定)
CS-凝固法的检测原理
凝固:将红光照射在血浆和试剂的混合物上
检测混浊度的改变即散射光的变化
测出凝结时间
散射光比浊的优点:
散射法信号可以通过提高激发光的强度为增强
散射光比浊的灵敏度是透射光比浊的100倍
散射光比浊不受低纤维蛋白原及高血粘度的影响
散射光检测抗干扰
避免高脂黄疸和溶血对凝固时间的测定和干扰
可测低纤维蛋白原标本的凝固时间
发色底物法检测原理
发色底物法
血浆,试剂以及底物混合开始反应
测定在游离P-硝基苯胺中的色素消失的变化

CRP-(全自动特定蛋白分析仪)
认识:C-反应蛋白(CRP)是一种急性相蛋白,且是在历史上首先被认识的急性相蛋白之一
CRP分析仪可以快速测定血液中C-反应蛋白的含量
C-反应蛋白含量与血液分析仪测定的白细胞数量的联用,可以快速鉴别诊断病毒和细菌感染指导抗生素使用,监测病程状态
血常规检测和CRP检测的比较
血常规:感染时的反应速度:升高较慢,治疗有效后降低缓慢
CRP:变化快速,几小时即可升高,治愈后能快速降到正常水平
血常规:影响因素:年龄,妊娠与分娩药物
CRP:不受年龄,生理状态,药物治疗
鉴别诊断:不易鉴别细菌感染和病毒感染
能有效鉴别细菌感染和病毒感染
相关疾病的活动性:其数量的变化不能反映疾病的活动性
CRP的浓度与病程发展是正相关,CRP随着严重程度的发展浓度由低到高的发生变化,随着浓度恢复下降
CRP的临床意义:类风湿关节炎,系统性红斑狼疮,恶性肿瘤,急性白血病,肠胃疾病,生殖器感染,心肌梗塞
hs-CRP的临床意义:
hs-CRP用于诊断和预测心脑血管事件 的发生,发展
hs-CRP用于新生儿的细菌或者病毒感染,各种炎症的筛查,监测评估药物的疗效判断
PA-600(全自动特定蛋白分析仪)
规格:适应环境:10-35摄氏度,湿度:小于等于百分之70
性能参数:
检测方法:免疫散射比浊法
检测通道:1个。检测速度:36
试剂规格:250T
1,CRP反应液 2,CRP清洗液,3 水平1质控品 4,水平2质控品 5CRP抗血清 6RFID磁卡 7比色杯 8,磁性搅拌棒 9,消泡剂
免疫散射比浊法的优势:
灵敏度高,检测速度快,准确性高,精密度高
抗血清和比色杯安装
1,首先打开二维臂的z轴,便于放入比色杯
2,拔出比色杯,再放入一个比色杯
3,向反应杯放入一个磁性搅拌子
4,打开抗血清试剂瓶盖,并把该试剂瓶放入试剂位
5,开机情况下更换比色杯
先点击系统--常规维护--更换比色杯--
开机:
检查仪器的各个部分
PA-900
检测方法:免疫散射比浊法
通道:3个通道,速度:100
注意:1,试剂有效期为一年,开瓶为三个月
装机试剂规格为250T,为常规试剂的一半
免疫散射比浊法:溶液中的微粒受到光线照射后,微粒对光线产生反射和折射形成散射光
CRP和hs-CRP的区别:
超敏C-反应蛋白和普通C-反应蛋白是同一种物质只是检测方法和底限不同,采用先进的技术大大提高了分析灵敏度
注意:CRP仪器是附属于血常规仪器,因此在安装前需要安装血常规的仪器的laboman
样本与质控的测试
当用全血测试时,样本类型必须选择全血(全血线性范围为0.5-370毫克每升)
当用血清测试时,样本类型必须选择血清(血清的线性范围是0.3-222毫克每升)
激光模组
激光模组是整个仪器的核心部件,包含激光模组发射器和接收器,模组尾端发射的激光,通过测量杯散射,散射的光由信号接收实时接收并处理信号,再将处理的信号传导主板上计算得出结果
携带污染:
光电比色计的基本结构
利用光电池或光电管等光电转换元件作检测器,来测量通过有色溶液后透射光的强度,从而求出被测物质含量的方法叫做光电比色法。基于此设计的仪器叫做光电比色计。一般的光电比色计由光源,滤光片,比色皿,光电检测器,放大和显示等六部分组成。
光源发出的复合光经滤光片滤波后,变为近似的单色光。此单色光通过比色皿时,被里面的样品吸收掉一部分,然后照射在光电检测器上。光电检测器将光信号的强弱转变为电信号的大小,最后经放大,由显示部分显示出测量结果
UC-3500日常保养






























UF-5000的校准(灵敏度,电导率,总计数)
一,电导率调整




二,灵敏度调整











三,总计数校准






TU-40的安装



最后
以上就是沉静导师最近收集整理的关于硬件工程师--医疗器械的全部内容,更多相关硬件工程师--医疗器械内容请搜索靠谱客的其他文章。
发表评论 取消回复